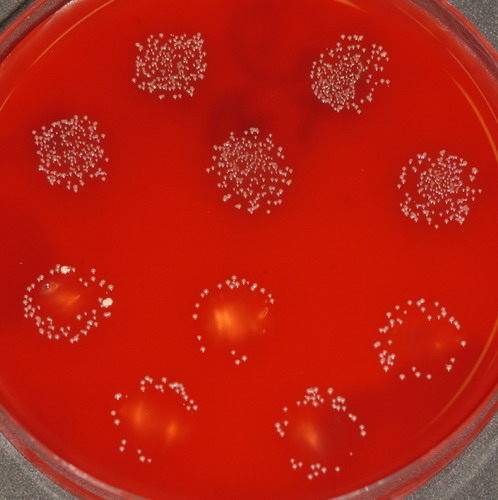

Masterthese 2007
Bakterizide Wirkung des gepulsten Nd:YAG – Lasers auf Prevotella intermedia und Actinobacillus actinomycetemcomitans

Eine dosimetrische In-vitro-Studie
von
Dr. med. dent. M. Sc. Peter Kleemann
Eine dosimetrische In-vitro-Studie
von
Dr. med. dent. M. Sc. Peter Kleemann